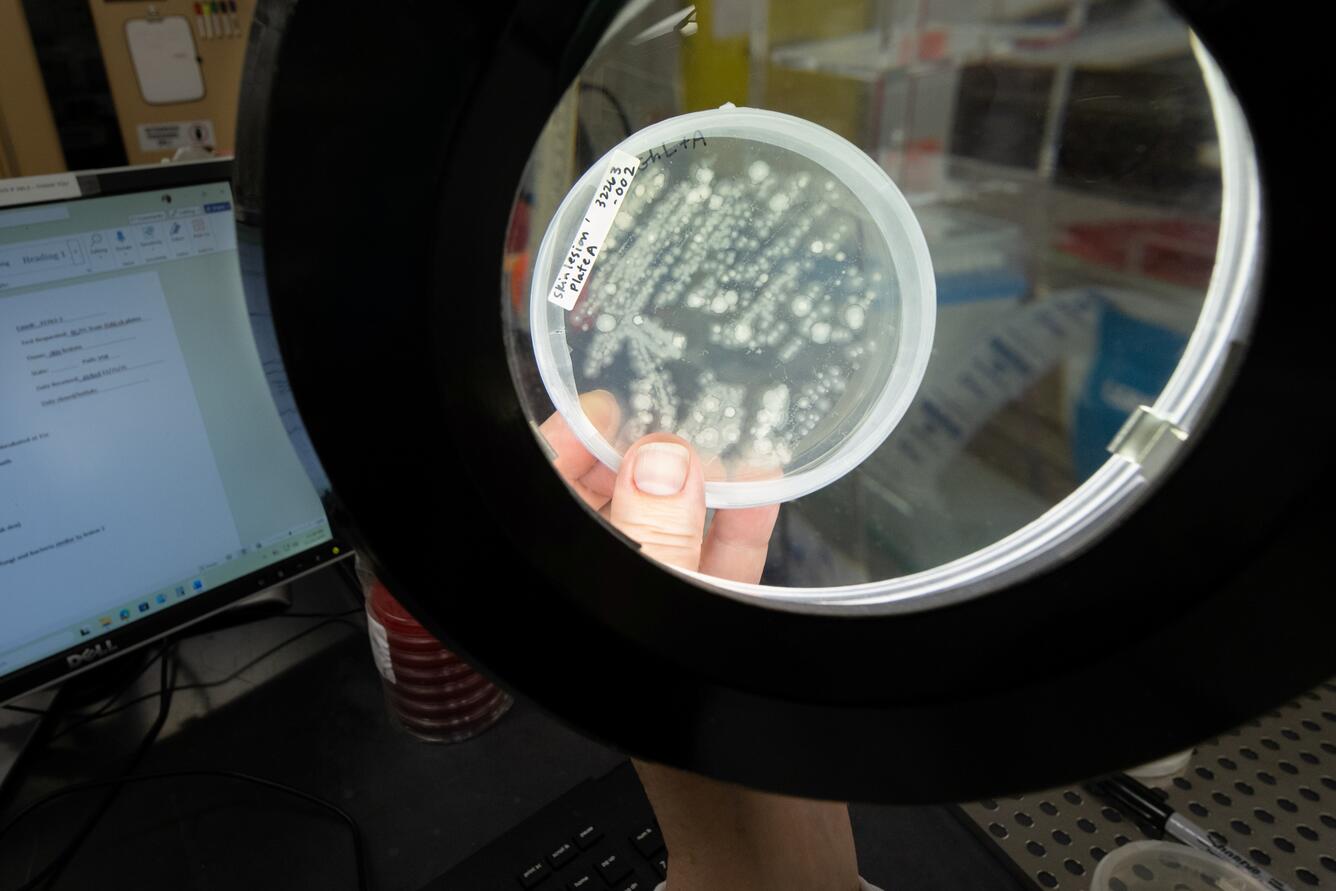
A scientist holds a petri dish under a light. Inside the dish are microorganisms taken from salamander skin.

Scientists investigate pathogens in salamanders

Detailed Description
A USGS scientist examines microorganisms from salamander skin to investigate for potential pathogens.
Sources/Usage
Public Domain.
A USGS scientist examines microorganisms from salamander skin to investigate for potential pathogens.
Public Domain.